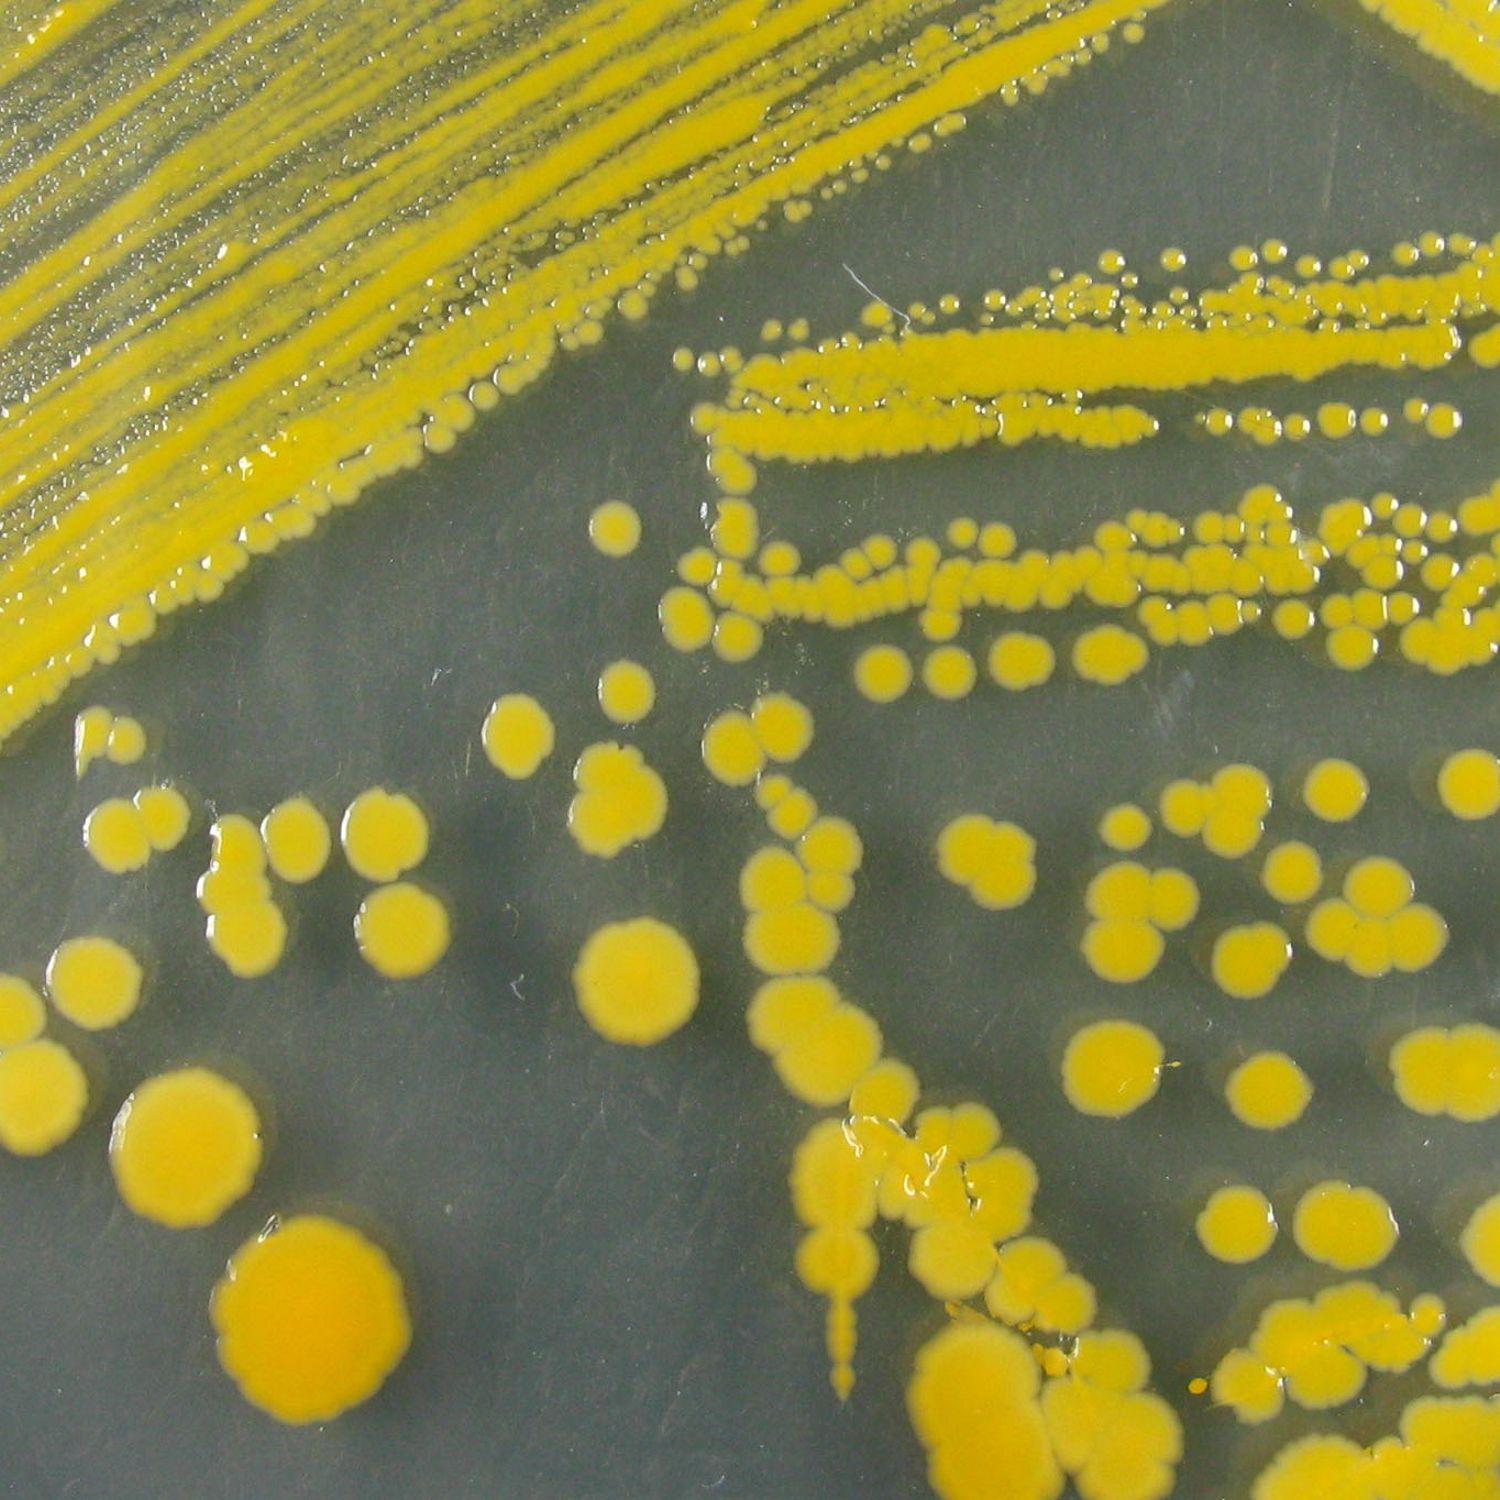
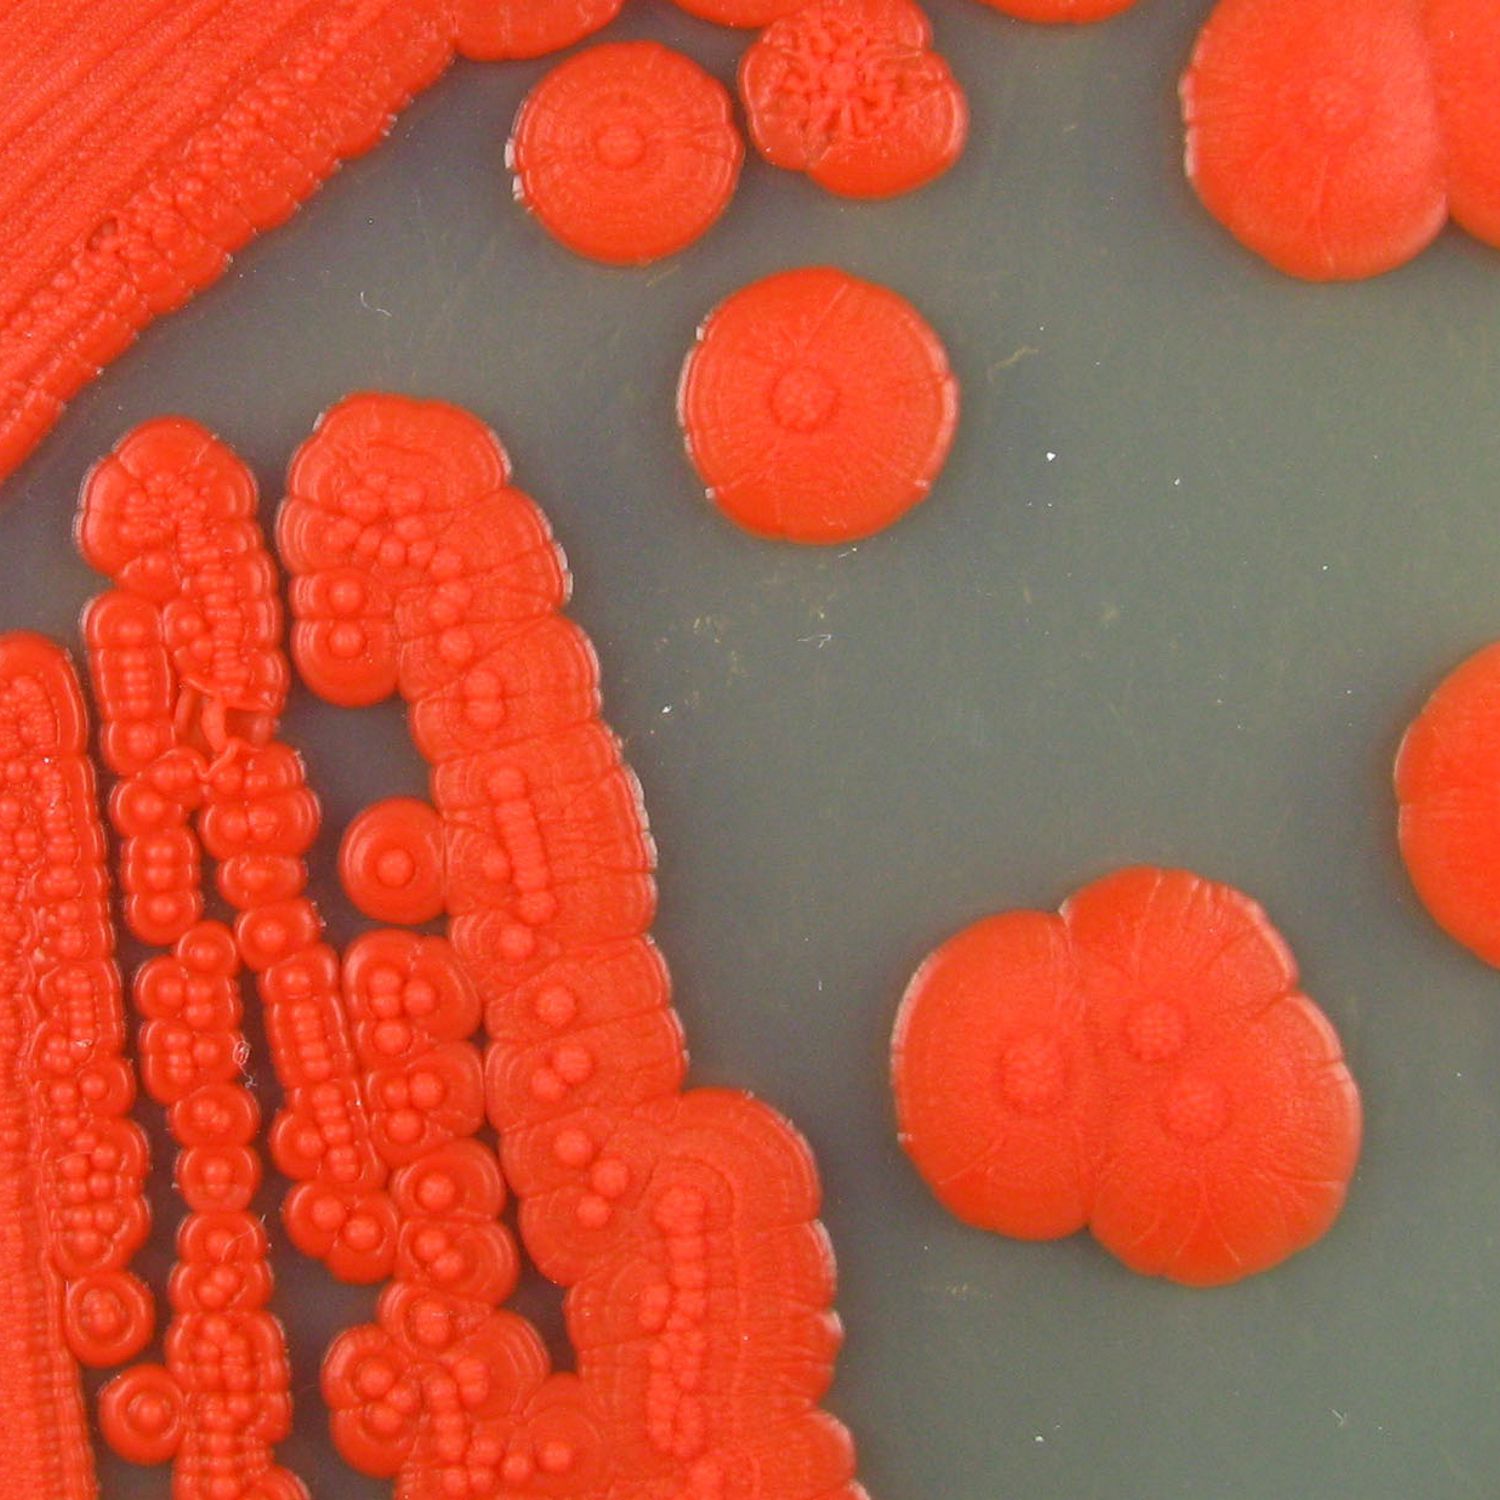
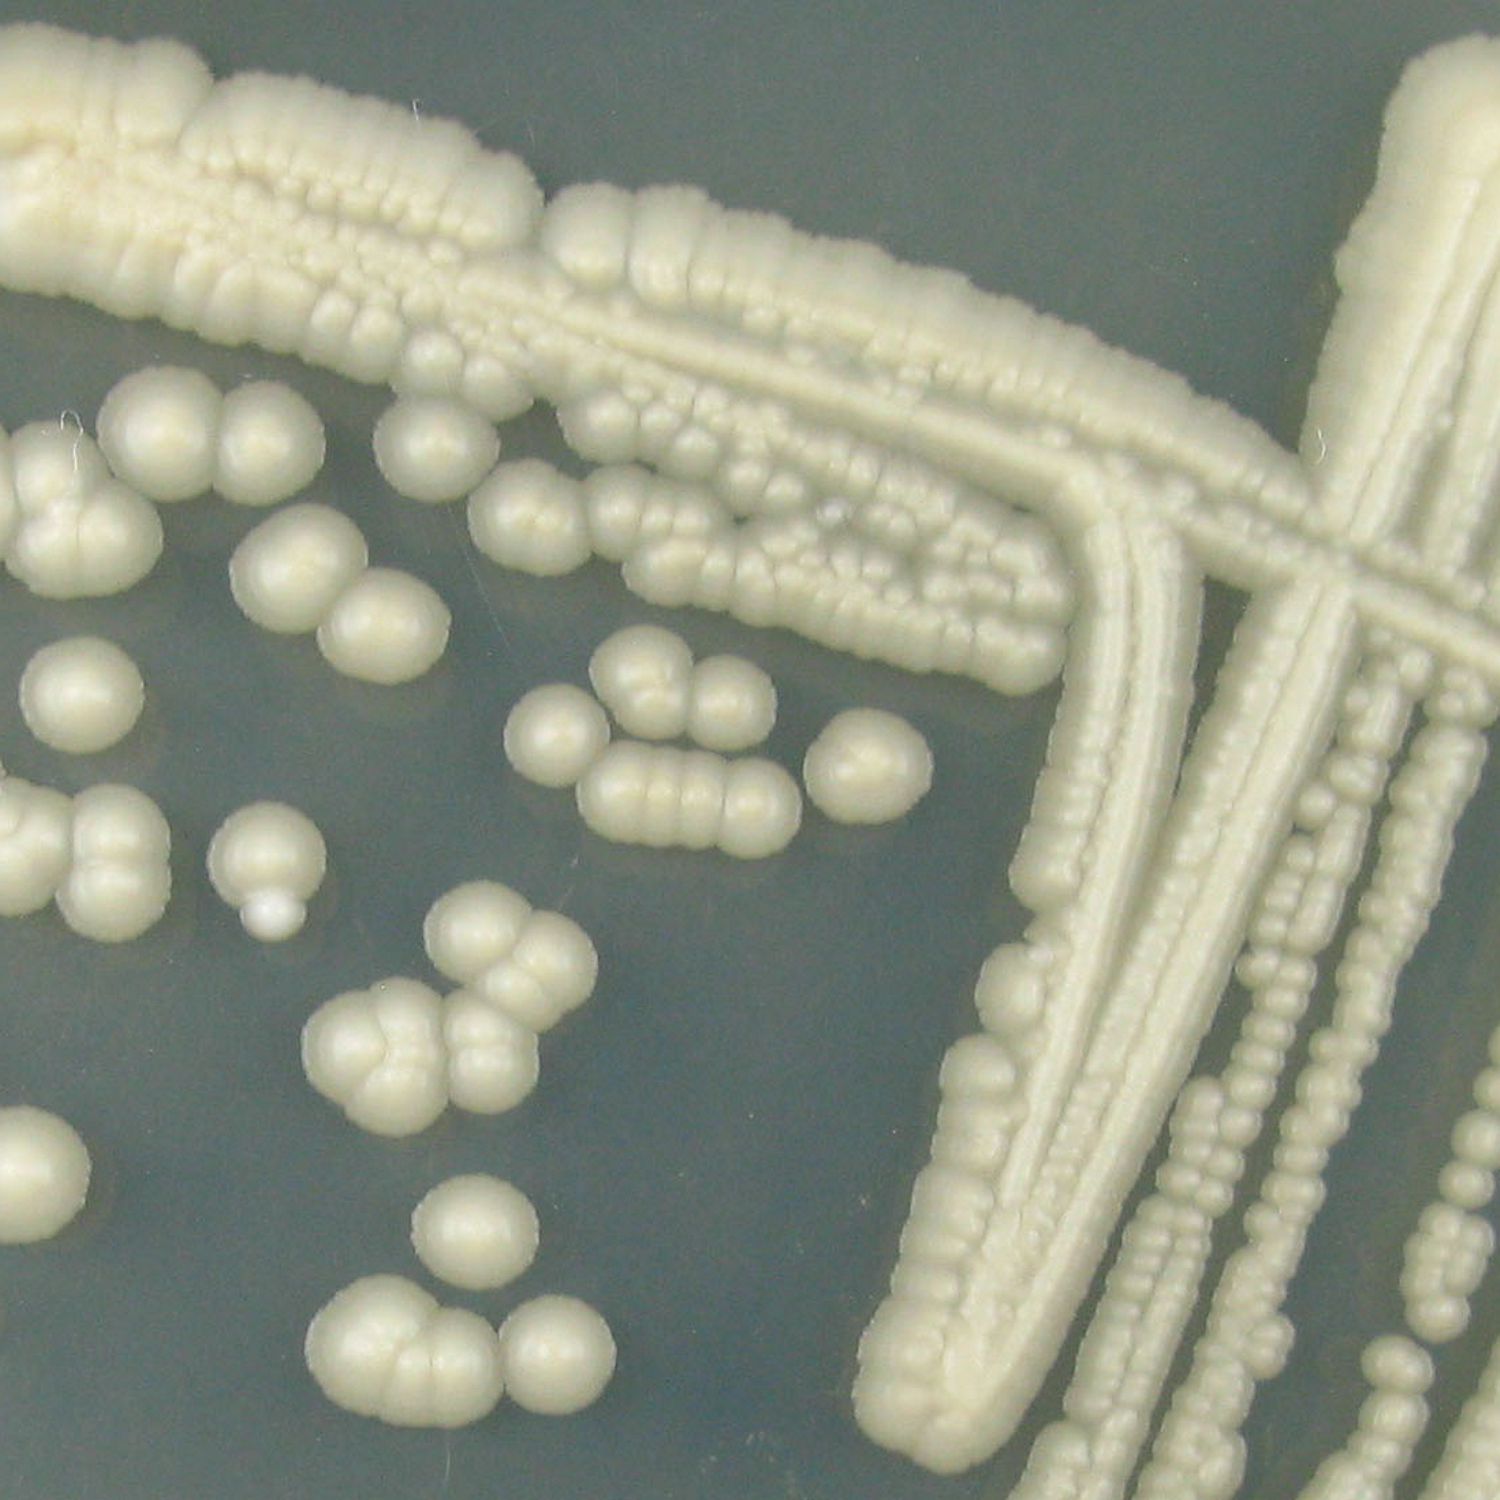

Commonly, members of the collection are deployed in the bioaugmentation efforts, or at the biodegradation fields, both either for contract or R&D purposes. There are lyophilised bacterial and yeast strains used for the degradation of crude oil products, phthalates, chlorinated ethylenes, BTEX, MTBE, etc. Among others, the collection contains taxa of Pseudomonas, Gordonia, Rhodococcus, Variovorax, or Kocuria.